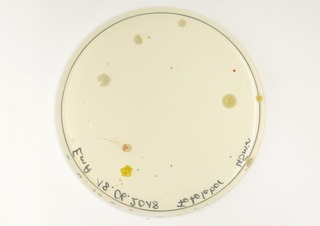
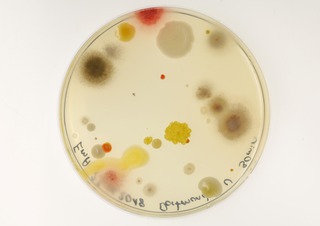
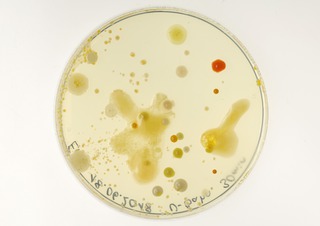
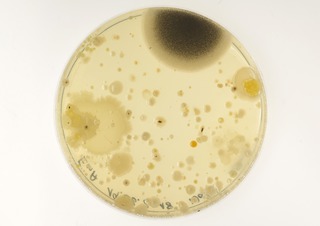
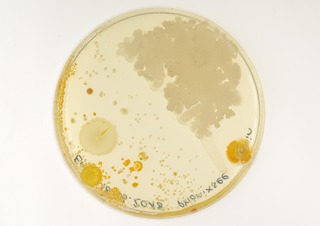
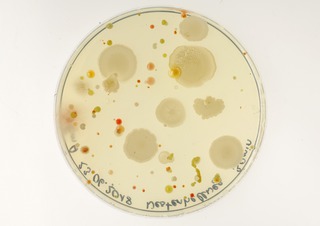
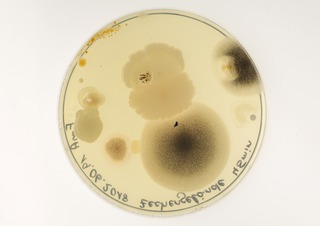
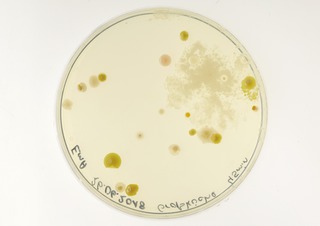

mittendrin - TU Dortmund
Invisibilia species
<h1>Invisibilia species</h1>
<h2>KATRIN STÜER-PATOWSKY</h2>
<p>Die makroskopisch sichtbare Welt, in der wir uns jeden Tag bewegen, ist zugleich Schauplatz vieler mikroskopischer Lebensgemeinschaften. In der Arbeit der Bioingenieurin...</p>
Invisibilia species
Katrin Stüer-Patowsky
Die makroskopisch sichtbare Welt, in der wir uns jeden Tag bewegen, ist zugleich Schauplatz vieler mikroskopischer Lebensgemeinschaften. In der Arbeit der Bioingenieurin Katrin Stüer-Patowsky wird die Luft Dortmunds als Lebensraum genauer betrachtet und mit Hilfe aufgestellter Luftkeim-Sedimentationsplatten dokumentiert. Exakt am gleichen Ort wurden auch Fotokameras positioniert; Betrachtende können die Umgebung mit den Augen der Mikroorganismen sehen. Auf diese Weise entsteht ein visueller Dialog zwischen dem Nicht-Sichtbaren und den Betrachtenden, die Aufmerksamkeit für die verborgenen Spezies im Alltag wird verstärkt.

JavaScript is turned off.
Please enable JavaScript to view this site properly.